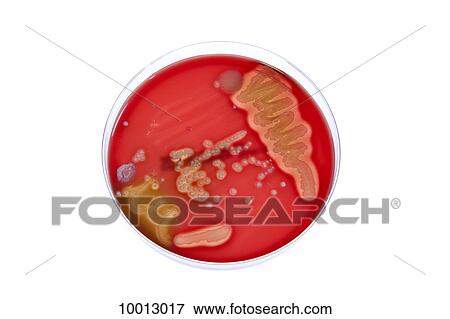

Fotosearch Royalty Free Stock Photography
Digital images licensed by Publitek, Inc.
Fotosearch and Photosearch are trademarks of Fotosearch, LLC
All rights reserved © 2026-06-06
A bacteria culture growing in a Petri dish Stock Photo
A bacteria culture growing in a Petri dish
10013017 | fStop | Royalty Free
Add to Lightbox
Share Image
Property Released
There is a signed property release for this image.
Keywords
bacterium, biology, close-up, color, control, cultured, development, directly above, discovery, growth, healthcare and medicine, horizontal, ideas, laboratory, laboratory equipment, medical research, medical research equipment, microbiology, no people, petri dish, photography, research, science, science and technology, scientific experiment, selective focus, series, single object, still life, studio shot, unknown, white background, stock image, images, royalty free photo, stock photos, stock photograph, stock photographs, picture, pictures, graphic, graphics, fine art prints, print, poster, posters, mural, wall murals, 10013017
bacterium, biology, close-up, color, control, cultured, development, directly above, discovery, growth, healthcare and medicine, horizontal, ideas, laboratory, laboratory equipment, medical research, medical research equipment, microbiology, no people, petri dish, photography, research, science, science and technology, scientific experiment, selective focus, series, single object, still life, studio shot, unknown, white background, stock image, images, royalty free photo, stock photos, stock photograph, stock photographs, picture, pictures, graphic, graphics, fine art prints, print, poster, posters, mural, wall murals, 10013017
Show Keywords
- Mobile/Small Web Resolution (150 KB)3.9" x 2.6" @ 72dpi JPG16
- Web Resolution (500 KB)7.1" x 4.8" @ 72dpi JPG32
- Medium Resolution (10 MB)7.6" x 5.1" @ 300dpi JPG235
- High Resolution (28 MB)12.8" x 8.5" @ 300dpi JPG310
- Ultra High Resolution (48 MB)16.7" x 11.2" @ 300dpi JPG320
View larger image sizes
View fStop license agreement



















